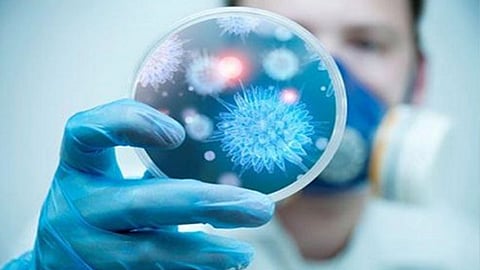

أعلن وزير الصحة الأفغاني فيروز الدين فيروز، اليوم الإثنين، تسجيل أول حالة إصابة بفيروس كورونا الجديد، وفقًا لما ذكرته قناة طلوع نيوز الأفغانية على صفحتها على موقع تويتر للتواصل الاجتماعي.
كما أعلن الوزير، حالة الطوارئ في إقليم هيرات غرب البلاد، الذي شهد تسجيل أول حالة إصابة بالفيروس.
وكانت وزارة الصحة العامة الأفغانية، قد أعلنت- أمس الأحد- تسجيل ثلاث حالات يُشتبه إصابتها بفيروس كورونا.
وذكر المتحدث باسم وزارة الصحة العامة، وحيد الله مايار، أن الأشخاص الثلاثة المصابين هم من سكان إقليم هيرات، الذين عادوا مؤخرًا من مدينة قم في إيران.
وأعلنت السلطات الصينية، اليوم، ارتفاع حالات الوفاة جراء فيروس كورونا الجديد، إلى ألفين و594 شخصًا، وإصابة 77 ألفًا و150 آخرين.
وأفادت اللجنة الحكومية للصحة، في بيان، أن عدد الوفيات جراء الفيروس خلال الساعات الـ24 الأخيرة، بلغ 150 شخصًا.
وظهر فيروس كورونا، لأول مرة، في 12 ديسمبر 2019 بمدينة ووهان (وسط)، إلا أن بكين كشفت عنه رسميًا منتصف يناير الماضي.
يُذكر أن منظمة الصحة العالمية، كانت قد أعلنت في وقت سابق، حالة الطوارئ على نطاق دولي لمواجهة تفشي الفيروس، الذي انتشر لاحقًا في عدة بلدان؛ ما تسبب في حالة رعب سادت العالم أجمع.
اقرأ أيضًا: